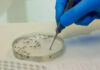
Vigilância Epidemiológica da Bahia atualiza casos de botulismo no estado Logo

A Polícia Rodoviária Federal (PRF) recuperou um carro furtado, na quarta-feira (15), e prendeu um suspeito de receptação. O caso aconteceu na Rodovia Presidente Dutra (BR-116), na Zona Norte do Rio.
Por volta das 17h, na altura da Pavuna, policiais rodoviários federais da 6ª Delegacia (Rio de Janeiro) abordaram um veículo. Em uma vistoria detalhada, verificaram que o carro circulava com uma placa clonada de outro automóvel da mesma marca e modelo. Logo após, a equipe da PRF constatou que o veículo era furtado. O crime aconteceu em 21 de março de 2025, na Zona Norte da capital fluminense. O motorista disse ter comprado o carro em uma plataforma de rede social.
A ocorrência foi encaminhada à Polícia Civil (39ª DP).